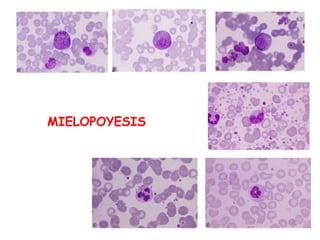
MIELOPOYESIS
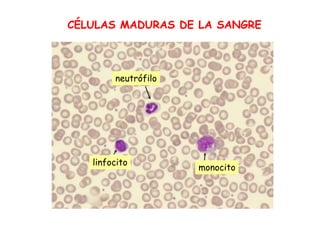
CÉLULAS MADURAS DE LA SANGRE
neutrófilo
monocito
linfocito

La hematopoyesis es el proceso mediante el cual se producen las células sanguíneas a través de la proliferación y diferenciación de células madre en la médula ósea. Incluye la eritropoyesis, mielopoyesis y megakariopoyesis, las cuales generan eritrocitos, leucocitos y plaquetas respectivamente, y está regulada por citoquinas. Los estudios de laboratorio como el hemograma y la punción de médula ósea son útiles para evaluar la hematopoyesis.